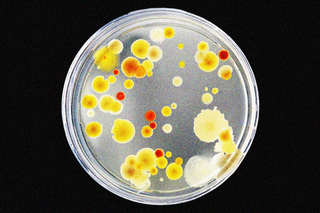

Scientists Find New Way To Fight Antibiotic Resistance in Dangerous Bacteria
If successful, the treatment can prevent more deaths annually than those caused by AIDS or malaria.
In a medical breakthrough that could save millions of lives, scientists have found a way to potentially disarm bacteria that develop resistance to antibiotics.
A team of researchers from the University of Texas, Austin, found a way to do this by inhibiting a particular protein in disease-causing bacteria. This protein is responsible for driving resistance capabilities within the bacteria, and inhibiting it would essentially reverse the process to make them vulnerable to antibiotics again.
The study documenting these results was published yesterday in eLife. Bacteria such as E. coli and those that cause pneumonia are particularly deadly, and are reportedly responsible for most resistance-related infections. Antibiotic resistance is a crisis of a magnitude we haven’t yet come to terms with — a phenomenon that leaves us defenseless against deadly bacteria, killing more people globally every year than malaria and AIDS, according to a 2019 Lancet analysis.
India, in particular, is one of the epicenters for antibiotic resistance. “Most concerningly, its incidence of colistin resistance — that is, resistance to a drug of last resort, used only when all other antibiotics have failed — is increasing,” Liesl Goecker wrote for The Swaddle in 2020. Reasons behind it range from overprescription of antibiotics to pharmaceutical pollution, and overuse of antibiotics in livestock. Recent research also found that completing a “full course” of antibiotics can drive the phenomenon.
Related on The Swaddle:
Indian Newborns Are Dying of Antibiotic‑Resistant Infections
The problem got much worse during the pandemic, according to a study that looked at antibiotic usage in India during Covid19. Despite the infection being viral, doctors prescribed (and patients self-medicated themselves with) antibiotics — compounding what the World Health Organization called one of 10 of the biggest global health threats.
The fault is also with our healthcare system. “The researchers pointed out the reasons: private healthcare in India is largely unregulated, coupled with the economic disadvantages of a greater part of the population — leading medical professionals to often overprescribe antibiotic drugs,” wrote Devrupa Rakshit for The Swaddle, last year.
The new study provides hope for a situation that is rapidly spiraling out of control. “It’s a completely new way of thinking about targeting resistance… Other approaches focus on inhibiting resistance proteins, but nobody had thought to try and prevent their formation in the first place” said Despoina Mavridou, lead researcher of the study.
Antibiotic resistance works like this: certain proteins in the bacteria need to be folded into the right shapes to drive resistance. This shape-shifting is important because it allows bacteria to be undetectable by the human immune system. Bacteria also adapted to break down their own cell walls to resemble human cells, thereby evading antibiotics that target cell walls in particular.
Related on The Swaddle:
Scientists Have Developed a New Antibiotic That Works Against Resistant Strains of Bacteria
“Some of the most harmful pathogens belong to a group called the ‘Gram-negative bacteria’, which have an outer layer — called the cell envelope — that acts as a drug barrier. This envelope contains antibiotic resistance proteins that can deactivate or repel antibiotics or even pump them out of the cell once they get in. One way to tackle antibiotic resistance could be to stop these proteins from working,” the paper states. A particular protein, called DsbA, helps the other proteins to fold in these ways.
In the present study, scientists used a chemical (which isn’t safe to use in humans just yet) to inhibit DsbA. “Further experiments showed that blocking DsbA with a chemical inhibitor in other pathogenic species of Gram-negative bacteria made these bacteria more sensitive to antibiotics that they would normally resist,” the researchers wrote.
Researchers have previously only suspected that DsbA is responsible for folding proteins to evade antibiotics. Previously, its established role was in helping the spread of toxins in human cells. The current study is therefore a proof-of-concept study that proves DsbA’s role in antimicrobial resistance, by showing that inhibiting this protein reverses the process.
The next steps for the research are to combine DsbA inhibitors with existing antibiotics. “Since the discovery of new antibiotics is challenging, it is crucial to develop ways to prolong the lifespan of existing antimicrobials,” said Christopher Furniss, one of the lead authors of the study.
Rohitha Naraharisetty is a Senior Associate Editor at The Swaddle. She writes about the intersection of gender, caste, social movements, and pop culture. She can be found on Instagram at @rohitha_97 or on Twitter at @romimacaronii.
Related


Why People Are Quite Likely to Be Unhappy in Countries Ranking High on Happiness
